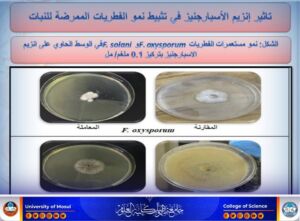
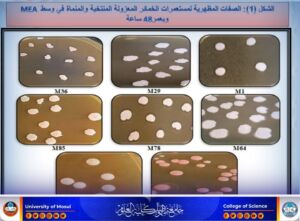
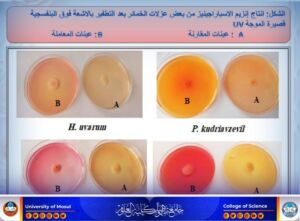

13 أغسطس، 2025
أطروحة دكتوراه تناقش تأثير التطفير الفيزيائي في إنتاج إنزيم L-Asparaginase من الخمائر المحلية

شهد قسم علوم الحياة في كلية العلوم – جامعة الموصل، يوم الأربعاء 13 آب 2025، مناقشة أطروحة الدكتوراه للطالبة مروة بدر فالح عبد الرحمن العبادي، الموسومة ” تأثير التطفير الفيزيائي على إنتاج إنزيم L-Asparaginase من بعض الخمائر المعزولة محلياً ودراسة بعض تطبيقاته الحيوية ” حضر جانباً من المناقشة السيدة عميد كلية العلوم الأستاذ الدكتورة هيام عادل إبراهيم، برفقة معاونيها للشؤون العلمية والإدارية، والسيد رئيس القسم، وعدد من تدريسي الكلية.
تناولت الدراسة جمع وعزل وتشخيص خمائر من أنواع مختلفة من الفواكه وأوراقها وتربتها في مدينة الموصل/العراق، بالاعتماد على الطرق المظهرية والكيموحيوية والجزيئية باستخدام تقنية PCR، وأسفر البحث عن تسجيل ثماني سلالات خمائر لأول مرة في بنك الجينات العالمي NCBI..
أظهرت النتائج تميز السلالة M. guilliermondii M120 في إنتاج إنزيم L-Asparaginase، وزيادة إنتاجيتها بعد تعريضها للأشعة فوق البنفسجية (254 نانومتر). كما أظهر التطفير الفيزيائي تحفيز سلالات أخرى مثل P. kudriavzevil M64، H. uvarum M85، وR. mucilaginosa M92 على إنتاج الإنزيم.
تم استخلاص الإنزيم من السلالة الأعلى إنتاجاً، وتنقيته وتجفيفه بتقنية Lyophilization، ثم توظيفه في تطبيقات حيوية مهمة، شملت :
- تثبيط نمو بعض الفطريات الممرضة للنبات.
- تقليل نشاط الجينات FOW-1 وSIX6 المسببة لأمراض الذبول الوعائي وتعفن الجذور.
- تقييم السمية الخلوية MTT على خطوط خلايا سرطانية HL-60 وK-562، مقارنة بخط الخلايا الطبيعية HdFn، حيث تبين أن خط K-562 كان الأكثر حساسية، ليُستخدم لاحقاً في فحص High Content Screening (HCS).
- دراسة تأثير رواشح الخميرة على نمو نبات Geranium كبدائل نمو صديقة للبيئة تدعم أهداف التنمية المستدامة.
ترأس لجنة المناقشة الأستاذ الدكتور مثنى جاسم محمد خلف، وعضوية كل من: الأستاذ الدكتور محمد إبراهيم خليل إبراهيم، الأستاذ المساعد الدكتورة ورقاء سعيد قاسم محمد، الأستاذ المساعد الدكتورة أنفال مؤيد جلال الدين سليمان، الأستاذ المساعد الدكتور رمضان يوسف محمد يوسف، وبإشراف وعضوية الأستاذ الدكتور أمجد عبد الهادي محمد والأستاذ المساعد الدكتورة بادية عبد الرزاق جمال.
وفي ختام المناقشة، قدمت السيدة عميد الكلية كتاب شكر وتقدير إلى رئيس اللجنة الأستاذ الدكتور مثنى جاسم محمد خلف، وإلى الأستاذ المساعد الدكتور رمضان يوسف محمد يوسف من جامعة صلاح الدين – أربيل، تقديراً لجهودهما العلمية وتحملهما عناء السفر.
شعبة الإعلام والاتصال الحكومي
الاربعاء 13 اب 2025